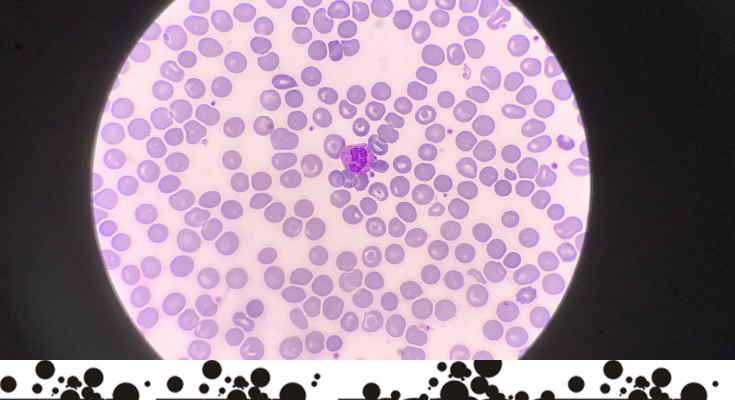

Tratarea obezității ar putea avea un ajutor nesperat: o moleculă existentă în sângele pitonilor.

Iulia Sîrghi ne explică, la NEXT LEVEL, cum s-a ajuns la acest stadiu al cercetărilor.
ACEEAȘI RUBRICĂ


Tratarea obezității ar putea avea un ajutor nesperat: o moleculă existentă în sângele pitonilor.
Iulia Sîrghi ne explică, la NEXT LEVEL, cum s-a ajuns la acest stadiu al cercetărilor.
ACEEAȘI RUBRICĂ